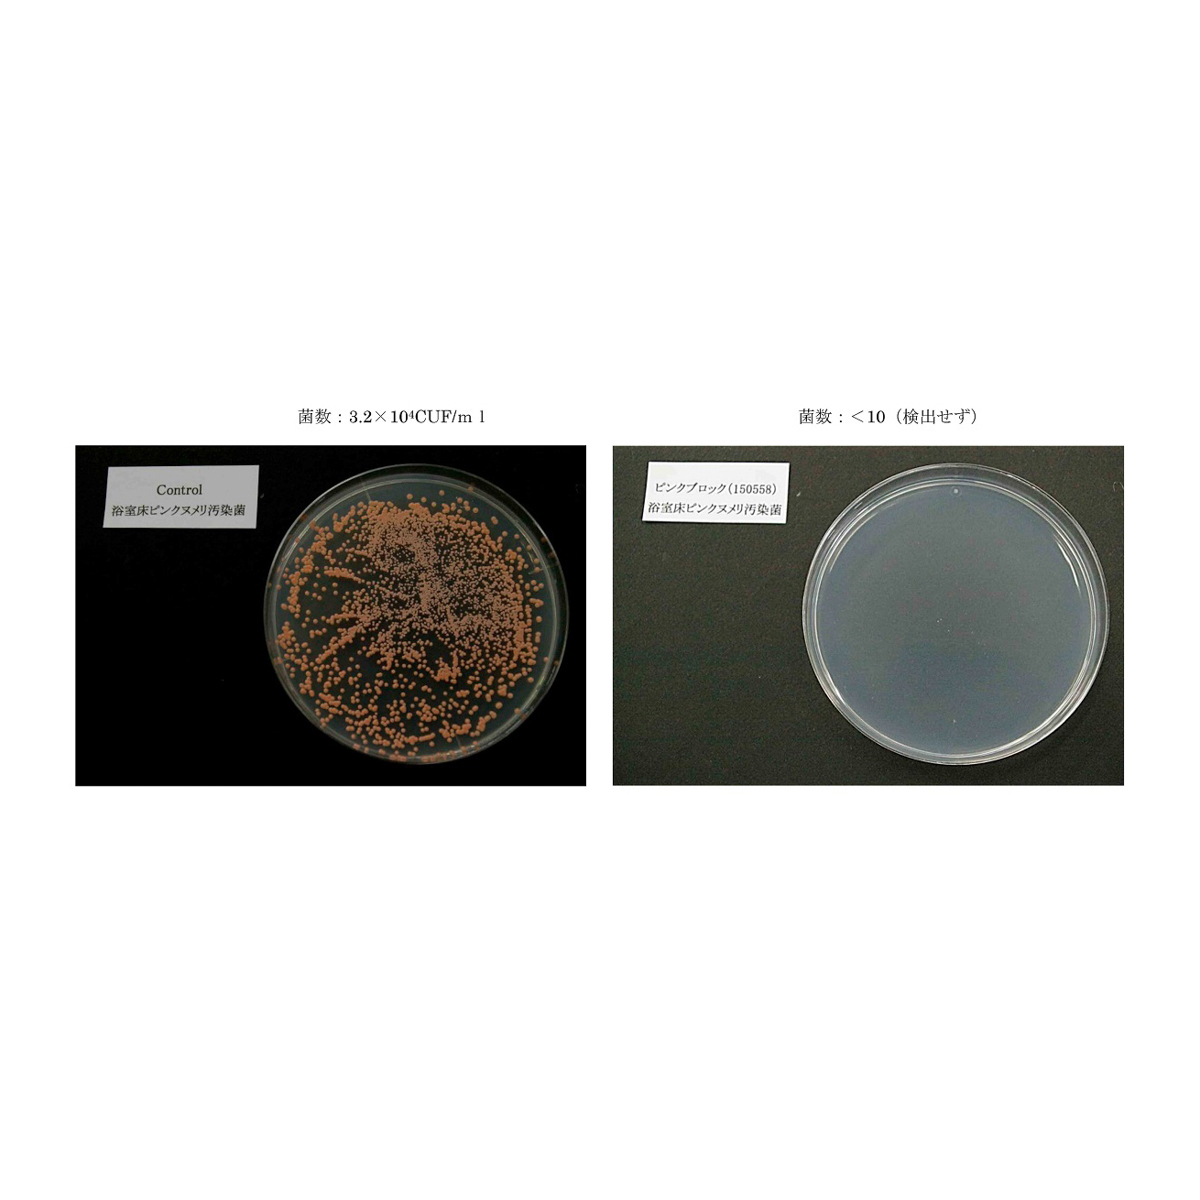
ピンクブロック

ご案内
カテゴリ
食品
飲料
ファッション
インナー・下着・ナイトウェア
美容・健康
医薬品
ベッド・寝具・布団
生活用品
キッチン用品・食器
日用消耗品・トイレタリー
家電・電化製品
家具・インテリア
文房具
伝統工芸品
ベビー・キッズ用品
ペットフード・ペット用品
お酒・ノンアルコール飲料
戻る
インナー・下着・ナイトウェア
インナー・下着・ナイトウェア全て レディースインナー・下着 レディースナイトウェア レディース靴下・タイツ・ストッキング メンズインナー・下着 メンズナイトウェア メンズ靴下
戻る
キッチン用品・食器
キッチン用品・食器全て キッチン消耗品 洗剤 水まわり商品 鍋・フライパン キッチン家電 食器・カトラリー カップ・ソーサー 湯のみ・グラス・タンブラー キッチン用品・調理器具 弁当箱
戻る